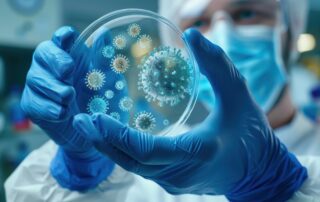

LA CATASTROPHE DES BÉBÉS NÉS SANS BRAS : UN PESTICIDE RESPONSABLE.. (Mise à jour Avril 2025)
L’AGRICULTURE PRODUCTIVISTE PLUS IMPORTANTE QUE LA SANTE HUMAINE ? Ce médicament responsable de la naissance des Bébés nés sans bras, au moins 10 000 dans près de 50 pays, fut prescrit dans les année 1960-1970 … Le thalidomide devenu fungicide. Une erreur médicale majeure "Il n’y pas que le glyphosate monsieur le sénateur !" L’excellent article paru le 16 mai dans le quotidien MEDIAPART mérite d’être cité en exemple, suite à un documentaire de 24 minutes de la télévision Suisse RTS. « Scandale de la Thalidomide: le fabricant allemand de ce médicament présente ses excuses aux milliers d’enfants victimes de malformations
Les 12 causes du Cancer de la Prostate
Connaître les 12 causes du cancer de la prostate pour l'éviter et/ou éviter les récidives UN FLÉAU SOCIAL pour 1 homme sur 8 et 1 homme sur 7 à partir de 70 ans Les chiffres : nombre de nouveaux cas et gravité Notre objectif : réduire chaque année le nombre de nouveaux cas d’hommes atteints par le cancer de la prostate. En France : 66.000 cas en 2020 Dans le monde 1,4 million en 2020 et 375.300 décès En 2017 on comptait en France 643 156 cas en cours de traitements. Troisième cause de décès
Les 12 causes des Cancers du Sein
La prévention des cancers du sein pour les éviter LE DÉPISTAGE DES CANCERS DU SEIN POUR DIAGNOSTIQUER LE PLUS TÔT POSSIBLE : Les 12 causes connues du fléau des cancers du sein en France 1 femme sur 8 61 214 NOUVEAUX CAS de FEMMES atteintes en 2023 PLUS DE 900 000 FEMMES ATTEINTES EN FRANCE Pour fabriquer 1 cm3 de tumeur mammaire il faut 5 à 8 ans (Pr Lucien Israël) 1000 cas de plus par an chez des femmes de plus en plus jeune 600 à 1000 Hommes atteins de cancer du sein chaque année
Votre microbiote et l’efficacité des traitements immunologiques contre les cancers
Chers amis de la santé, Je tiens à partager avec vous des avancées scientifiques de premier plan qui illustrent à quel point notre compréhension des liens entre le microbiote intestinal et la santé humaine ne cesse de progresser. Ces découvertes renforcent notre conviction que la médecine du futur sera résolument personnalisée, prenant en compte les spécificités de chaque individu, notamment son microbiote fortement dépendant de ses habitudes alimentaires, pour adapter les traitements et maximiser leur efficacité. L’immunothérapie, cette révolution thérapeutique dans le domaine du cancer, a montré des résultats spectaculaires chez certains patients. Cependant, tous ne réagissent
Fibromyalgie et posturologie
Chers amis de la santé, Je souhaite aujourd'hui aborder un sujet délicat et souvent mal compris : la fibromyalgie. Après le webinaire que nous avons donné à ce sujet, que vous pouvez retrouver ici : https://www.famillessanteprevention.org/webinaire/comment-vivre-avec-la-fibromyalgie/, nous avons reçu de très nombreuses questions auxquelles nous avons essayé de répondre. Nous avons longuement évoqué le rôle de l’alimentation comme outil de travail important, car elle peut être modulatrice de la douleur et de l’inflammation. Nous avons aussi évoqué un aspect physiologique peu connu, dont j’aimerai vous parler. Pour cela, j'ai invité mon ami le Dr Gérard Dieuzaide, dentiste et posturologue, à partager ses connaissances et ses
Les hormones prescrites aux femmes sont responsables de fléaux sociaux
Chers amis de la santé, Depuis bientôt 40 ans, j'affirme, preuves scientifiques à l’appui, que les progestatifs prescrits trop longtemps autour de la ménopause et les contraceptifs des pilules, elles aussi prises trop longtemps, sont responsables de fléaux sociaux graves. En tant que professionnel de santé, il est de mon devoir de vous informer des risques associés à ces traitements. Ces dernières semaines, le Figaro titrait : « Un problème mondial » : une étude sur des progestatifs confirme le risque de tumeur au cerveau. Leur article me donne malheureusement raison, une fois de plus. Je vous explique